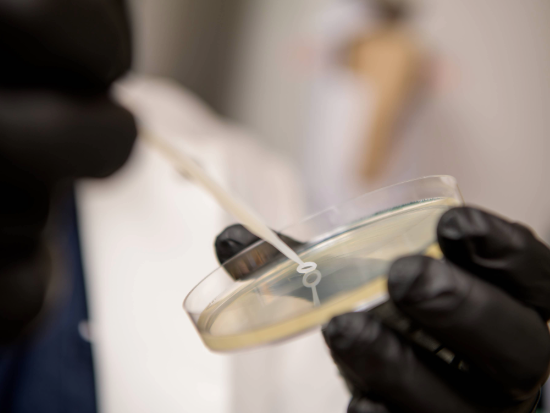

Graduate Biomedical Sciences (GBS) at UAB recently welcomed its new class of GBS students pursuing their Ph.D. across eight interdisciplinary training themes. The GBS Doctoral Training Program provides interdisciplinary education and mentorship while allowing GBS trainees to perform doctoral research in more than 350 labs across campus.
recently welcomed its new class of GBS students pursuing their Ph.D. across eight interdisciplinary training themes. The GBS Doctoral Training Program provides interdisciplinary education and mentorship while allowing GBS trainees to perform doctoral research in more than 350 labs across campus.
Neuroscience is among those themes. The GBS Neuroscience theme trains graduate students in laboratories across many departments at UAB, including Neurobiology, Neurology, Pathology, and Neurosurgery to name a few.
“We are excited to welcome our new cohort of students to the GBS Neuroscience theme at UAB,” said Michelle Gray, Ph.D., associate professor in the Department of Neurology. Gray’s fellow Neuroscience theme directors are Ryan Miller, M.D., Ph.D., and Neda Wick, M.D., both of the Department of Pathology. “These students bring a variety of research experiences to our program which is complemented by the areas of Neuroscience research being performed at UAB. They add to an already vibrant community of GBS Neuroscience theme students, and we look forward to seeing all of the amazing discoveries they will make.”
David Schneider, Ph.D., associate dean for Graduate Biomedical Sciences at UAB, expressed that the biomedical research this program supports is key to answering critical questions about human health.
"Biomedical research is more complex today than ever, and the pace of learning continues to accelerate," Schneider said. "The GBS program is dedicated to nurturing the curiosity of our trainees and equipping them with the skills to drive biomedical research forward in our state, in our country, and beyond."
The incoming GBS Doctoral Training Program trainees across all themes are as follows:
Biochemistry and Structural Biology
Md Simul Bhuiya
Jaci Fleming
Daniel Neidigk
Jason Neidigk
William Spanier
Apoorva Upreti
Cellular, Molecular, and Developmental Biology
Katherine Adriatico
Vaishnavi Balaji
Milana Egorova
Hayden Haupt
Charlie Smith
Woodland Smith
Olgierd Jan Talarowski
Thi Kieu Duyen Tran
Cancer Biology
Ankita Bhobe
Kevin Graciano
Brunno Macedo
Kelsey O’Brien
Bindu Papineni
Ashley Rennhack
Gaurav Seth
Parker Tamucci
Genetics, Genomics, Bioinformatics
Hira Gul
Craig Peters
Saeed Zakakhosravi
Ashlyn Anderson
Caroline Andrews
Sabrina Chowdhury
Abel Lopez
Katherine Marlow
Gabrielle Smith
Immunology
James Brazell
Zhongyi Dong
Qisen Guo
Nicholas Hill
Olivia Johnston
Rebecca Korankye
Pin-Yi Lee
Oladapo Oladipo
Darren Ty
Linpu Yang
Microbiology
Candace Barnes
Nowshin Jahan
Elizabeth Joiner
Anh Tuan Nguyen
Sarah Perritt
Neuroscience
Samuel Bartley
Carley Craig
Adela Harvey
Emma Hobby
Margaret Ireland
Odelia Johnson
Azariah Kaplelach
Arielle Manabat
Adora Norman
Md Sorwer Parvez
Mackenzi Prina
Ashley Thompson
Bryana Whitaker
Pathiobiology, Pharmacology, Physiology
Jaclyn Freeman
Jeffrey Horbatiuk
Mohammed Abdalla
Cheyenne Griffin
Victoria Harper
Sourajeet Karfa
Brittney Owens
Samantha Way
Bita Zandi